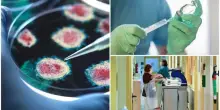

s

Genova, San Torpete riconoscerà lo stato di Palestina: non si può tacere senza tradire Vangelo e Costituzione
05-08-2025, 08:00
Dopo quattro anni di chiusura forzata (Sars-CoV II) e restauro radicale (facciate, tetti, cupola e interni), la Parrocchia di S.M. Immacolata e San Torpete nel centro storico di Genova riapre al pubblico della città e di fuori Genova. Lo facciamo con un atto di valore morale, politico, sociale e civile: domenica 14 settembre 2025, pubblicheremo […] L'articolo Genova, San Torpete riconoscerà lo stato di Palestina: non si può tacere senza tradire Vangelo e Costituzione proviene da Il Fatto Quotidiano.
CONTINUA A LEGGERE

20

0

0
Guarda anche
Il Fatto Quotidiano
19:36
“Clima di paura e bullismo”, costretta alle dimissioni l’amministratrice delegata di Oxfam Gran Bretagna
Il Fatto Quotidiano
18:46